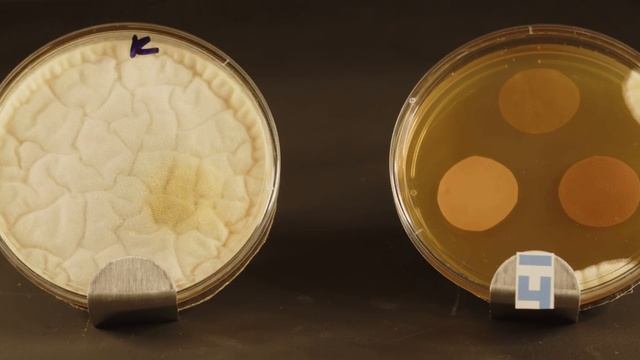

How can echocardiography guide fluid challenges Michelle Chew ISICEM-44 (2025)
Информация
11 апреля 2025 г. 14:23:12
00:15:54
Похожие видео
 Эксперимент с сыром
Эксперимент с сыром Русский газоанализатор с измерением ФОЕ Мазурок В.А. СПб 2025
Русский газоанализатор с измерением ФОЕ Мазурок В.А. СПб 2025 Нетрадиционные методы НИВ при COVID Ярошецкий А.И. 2021
Нетрадиционные методы НИВ при COVID Ярошецкий А.И. 2021 Информация из газоанализатора 2025 Ярошецкий А.И.
Информация из газоанализатора 2025 Ярошецкий А.И. Программа подготовки судоводителей маломерного флота ч.5
Программа подготовки судоводителей маломерного флота ч.5 Научная конференция КОСМОНООСФЕРНАЯ НАУКА
Научная конференция КОСМОНООСФЕРНАЯ НАУКА Практикум на ап Миндрей обсуждение Ковид Ярошецкий А.И.
Практикум на ап Миндрей обсуждение Ковид Ярошецкий А.И. Контроль качества продукции Чистех
Контроль качества продукции Чистех Понятие мощность в ИВЛ Горячев А.С. СПб 2025
Понятие мощность в ИВЛ Горячев А.С. СПб 2025 Марсоход Curiosity продемонстрировал, каким образом может выглядеть звездное небо с поверхности Марс
Марсоход Curiosity продемонстрировал, каким образом может выглядеть звездное небо с поверхности Марс алгоритмы этиологической диагностики 20.05.25г
алгоритмы этиологической диагностики 20.05.25г Тестирование действия биоцидной композиции Чистех в чашках Петри
Тестирование действия биоцидной композиции Чистех в чашках Петри Китай – это центр будущего, где роботы становятся
Китай – это центр будущего, где роботы становятся Круглый стол "Зеркало научно- технического прогресса. Институты памяти и коллекции", часть 2
Круглый стол "Зеркало научно- технического прогресса. Институты памяти и коллекции", часть 2 Демоэкзамен СДО площадка Митино 20.05.
Демоэкзамен СДО площадка Митино 20.05. Кардиогенный шок у беременных Баутин А.Е. СПб 2025
Кардиогенный шок у беременных Баутин А.Е. СПб 2025 НИВ при COVID на что внимание 2021 ЯрошецкийА.И.
НИВ при COVID на что внимание 2021 ЯрошецкийА.И. НИВ COVID важные мелочи 2021 Ярошецкий А.И.
НИВ COVID важные мелочи 2021 Ярошецкий А.И. Мир по учебнику географии 1908 года: Индия, Малайзия, Иран, Турция
Мир по учебнику географии 1908 года: Индия, Малайзия, Иран, Турция 1. Беляева Светлана Сергеевна, Блинов Владимир Игоревич
1. Беляева Светлана Сергеевна, Блинов Владимир Игоревич